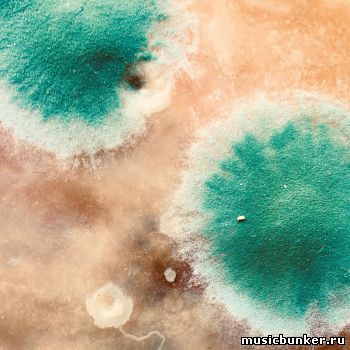

Label Label: Lobster Theremin Genre: Breakbeat, Deep House, House, Jungle, Techno Quality: FLAC (*tracks) 
|
 Label Label: MFF Genre: House Quality: FLAC (*tracks) 
|
 Label Label: Soundway – SNDWCD124 Genre: Soul, Disco, Boogie, Bubblegum Quality: FLAC (*tracks + .cue + log + scans) 
|
 Label Label: EMI – 4976672 Genre: Disco, Synth-pop, Pop Rock Quality: FLAC (*tracks + .cue + log) 
|
 Label Label: NWAQ – APE-LP02 Genre: Deep House, Deep Techno, Ambient Quality: FLAC (*tracks) 
|
 Label Label: Mule Musiq - 4250101419294 Genre: Ambient Quality: FLAC (*tracks) 
|
Label Label: Cosmo Rhythmatic - 5060165486182 Genre: abstract, ambient, experimental, experimental rock, free jazz, psychedelic, shamanic music Quality: FLAC (*tracks) 24 bit / 44.1 kHz 
|
|